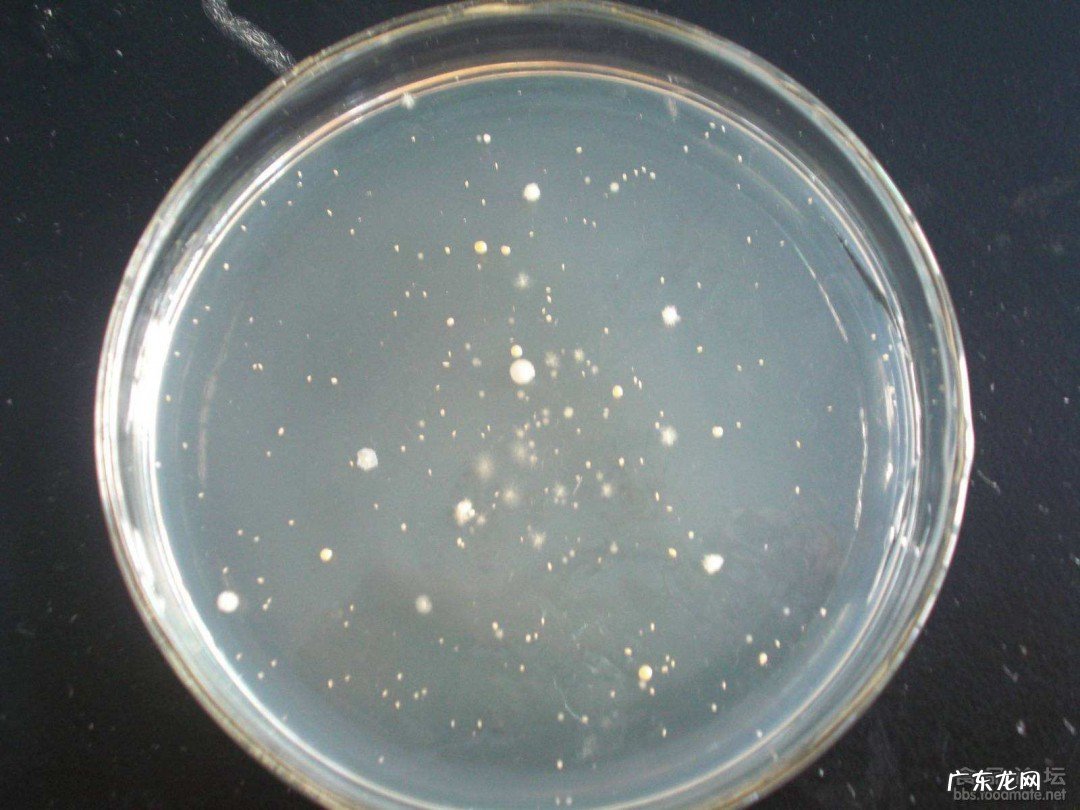

文章插图
【琼脂是什么东西】1、琼脂,学名琼胶,英文名(agar),又名洋菜(agar-agar)、海东菜、冻粉、琼胶、石花胶、燕菜精、洋粉、寒天、大菜丝,是植物胶的一种,常用海产的麒麟菜、石花菜、江蓠等制成,为无色、无固定形状的固体,溶于热水 。在食品工业中应用广泛,亦常用作细菌培养基 。为什么叫琼脂,主要是用海南的麒麟菜或石花菜制作出来的 。海南的简称就是琼 。
2、琼脂是由海藻中提取的多糖体,是目前世界上用途最广泛的海藻胶之一 。它在食品工业、医药工业、日用化工、生物工程等许多方面有着广泛的应用,琼脂用于食品中能明显改变食品的品质,提高食品的档次 。价格很高 。其特点是具有凝固性、稳定性等物理化学性质,能与一些物质形成络合物,可用作增稠剂、凝固剂、悬浮剂、乳化剂,保鲜剂和稳定剂 。广泛用于制造粒粒橙及各种饮料、果冻、冰淇淋、糕点、软糖、罐头、肉制品、八宝粥、银耳燕窝、羹类食品、凉拌食品等等 。琼脂在化学工业,医学科研,可作培养基,药膏基及其他用途 。
- 预测今年NBA全明星东西部首发分别有谁?
- 1220是什么星座
- 6月21日是什么星座
- 1月23日是什么星座
- 万能险的初始费用是什么意思
- 企业战略评估原则是什么
- 被动减持是什么意思
- 商业网点是什么?
- 回忆录是什么体裁
- 牙齿很黄是什么原因?怎么美白牙齿?
特别声明:本站内容均来自网友提供或互联网,仅供参考,请勿用于商业和其他非法用途。如果侵犯了您的权益请与我们联系,我们将在24小时内删除。
